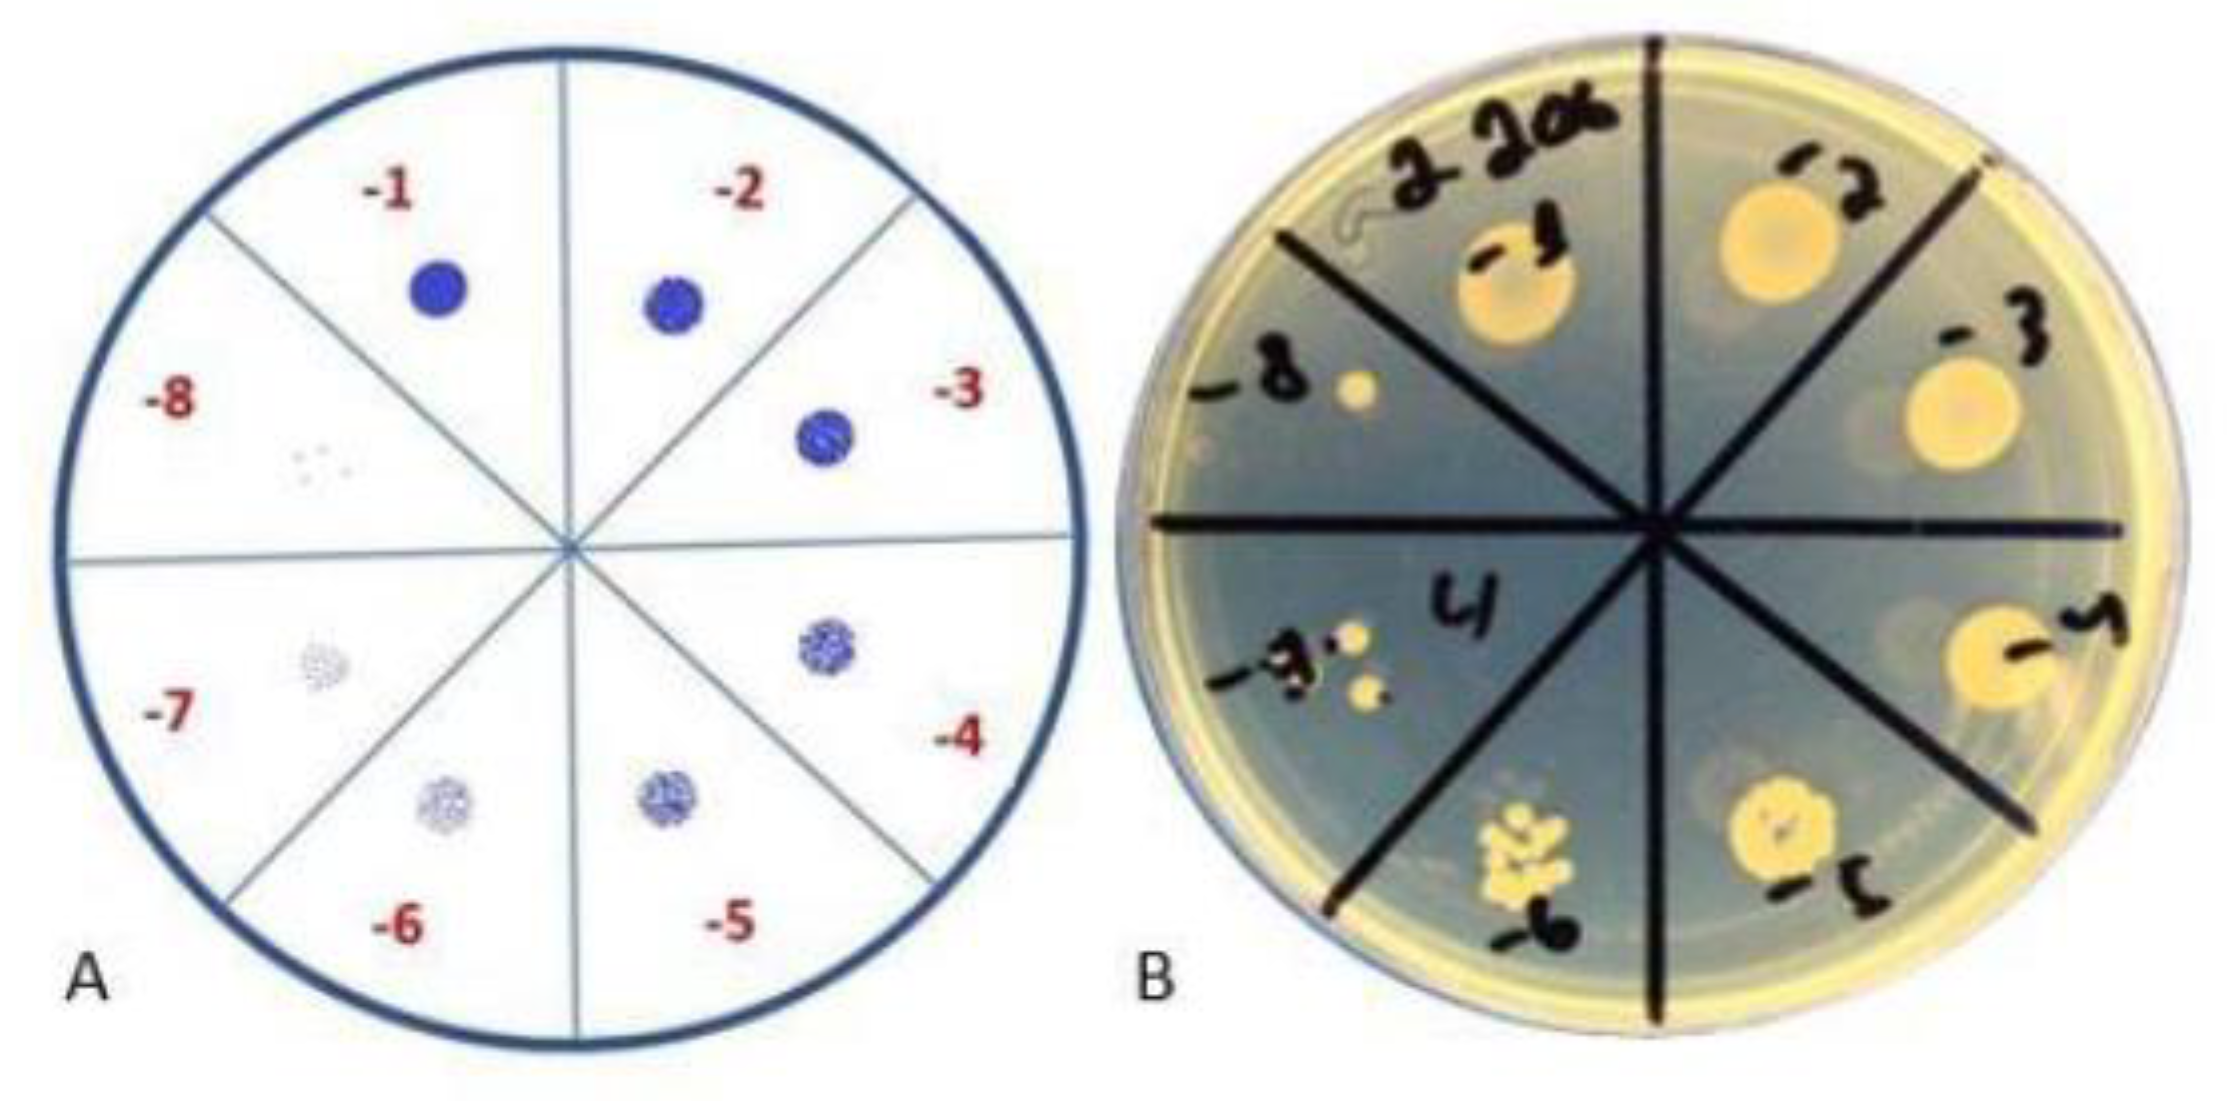

Anti-Biofilm Effect of Bacteriophages and Antibiotics against Uropathogenic Escherichia coli
Abstract
1. Introduction
2. Results
2.1. Bacterial Isolates
2.2. Biofilm Screening
2.3. Antimicrobial and Phage Susceptibility
2.4. Colony-Forming Unit Spot Test
2.5. Minimal Inhibitory Concentration (MIC) and Minimal Biofilm Eradication Concentration (MBEC) Detection
3. Discussion
4. Materials and Methods
4.1. Bacterial Isolates and Antimicrobial Susceptibility
4.2. Biofilm Screening
4.3. Bacteriophage Cocktails and Their Propagation
4.4. Spot Assay for Phage-Susceptibility Testing
4.5. Phage Adaptation Procedure
4.6. Minimal Inhibitory Concentration (MIC) and Minimal Biofilm Eradication Concentration (MBEC) Detection
4.7. Colony-Forming Unit Spot Test
4.8. Data Analysis
4.9. Ethical Statement
5. Conclusions
Author Contributions
Funding
Institutional Review Board Statement
Informed Consent Statement
Data Availability Statement
Conflicts of Interest
References
- WHO. Global Antimicrobial Resistance and Use Surveillance System (GLASS) Report. Available online: https://apps.who.int/iris/bitstream/handle/10665/341666/9789240027336-eng.pdf (accessed on 11 October 2022).
- WHO. 2019 ANTIBACTERIAL AGENTS IN CLINICAL DEVELOPMENT an Analysis of the Antibacterial Clinical Development Pipeline. Available online: https://apps.who.int/iris/bitstream/handle/10665/330420/9789240000193-eng.pdf (accessed on 11 October 2022).
- WHO. ANTIBACTERIAL AGENTS IN PRECLINICAL DEVELOPMENT an Open Access Database. Available online: https://apps.who.int/iris/bitstream/handle/10665/330290/WHO-EMP-IAU-2019.12-eng.pdf (accessed on 11 October 2022).
- WHO. 2021 ANTIBACTERIAL AGENTS IN CLINICAL AND PRECLINICAL DEVELOPMENT: An Overview and Analysis. Available online: https://apps.who.int/iris/bitstream/handle/10665/354545/9789240047655-eng.pdf?sequence=1&isAllowed=y (accessed on 11 October 2022).
- Kanwal Rehman, S.H.K.; Akash, M.S.H. Toxicity of antibiotics. Antibiot. Antimicrob. Resist. Genes Environ. Elsevier 2022, 1, 234–252. [Google Scholar] [CrossRef]
- Jennes, S.; Merabishvili, M.; Soentjens, P.; Pang, K.W.; Rose, T.; Keersebilck, E.; Soete, O.; François, P.M.; Teodorescu, S.; Verween, G.; et al. Use of bacteriophages in the treatment of colistin-only-sensitive Pseudomonas aeruginosa septicaemia in a patient with acute kidney injury-a case report. Crit. Care 2017, 21, 129. [Google Scholar] [CrossRef] [PubMed]
- Flores-Mireles, A.L.; Walker, J.N.; Caparon, M.; Hultgren, S.J. Urinary tract infections: Epidemiology, mechanisms of infection and treatment options. Nat. Rev. Microbiol. 2015, 13, 269–284. [Google Scholar] [CrossRef]
- Asadi Karam, M.R.; Habibi, M.; Bouzari, S. Urinary tract infection: Pathogenicity, antibiotic resistance and development of effective vaccines against Uropathogenic Escherichia coli. Mol. Immunol. 2019, 108, 56–67. [Google Scholar] [CrossRef]
- Klingeberg, A.; Noll, I.; Willrich, N.; Feig, M.; Emrich, D.; Zill, E.; Krenz-Weinreich, A.; Kalka-Moll, W.; Oberdorfer, K.; Schmiemann, G.; et al. Antibiotic-Resistant E. coli in Uncomplicated Community-Acquired Urinary Tract Infection. Dtsch. Arztebl. Int. 2018, 115, 494–500. [Google Scholar] [CrossRef] [PubMed]
- Lee, D.S.; Lee, S.J.; Choe, H.S. Community-Acquired Urinary Tract Infection by. Biomed. Res. Int. 2018, 2018, 7656752. [Google Scholar] [CrossRef]
- Trautner, B.W.; Darouiche, R.O. Role of biofilm in catheter-associated urinary tract infection. Am. J. Infect. Control 2004, 32, 177–183. [Google Scholar] [CrossRef] [PubMed]
- ETajbakhsh, E.; Ahmadi, P.; Abedpour-Dehkordi, E.; Arbab-Soleimani, N.; Khamesipour, F. Biofilm formation, antimicrobial susceptibility, serogroups and virulence genes of uropathogenic E. coli isolated from clinical samples in Iran. Antimicrob. Resist. Infect. Control 2016, 5, 11. [Google Scholar] [CrossRef]
- Shah, C.; Baral, R.; Bartaula, B.; Shrestha, L.B. Virulence factors of uropathogenic Escherichia coli (UPEC) and correlation with antimicrobial resistance. BMC Microbiol. 2019, 19, 204. [Google Scholar] [CrossRef]
- Chen, X.P.; Ali, L.; Wu, L.Y.; Liu, C.; Gang, C.X.; Huang, Q.F.; Ruan, J.H.; Bao, S.Y.; Rao, Y.P.; Yu, D. Biofilm Formation Plays a Role in the Formation of Multidrug-Resistant. Front. Microbiol. 2018, 9, 367. [Google Scholar] [CrossRef]
- Ballén, V.; Cepas, V.; Ratia, C.; Gabasa, Y.; Soto, S.M. Clinical Escherichia coli: From Biofilm Formation to New Antibiofilm Strategies. Microorganisms 2022, 10, 1103. [Google Scholar] [CrossRef] [PubMed]
- Lebeaux, D.; Ghigo, J.-M.; Beloin, C. Biofilm-related infections: Bridging the gap between clinical management and fundamental aspects of recalcitrance toward antibiotics. Microbiol. Mol. Biol. Rev. MMBR 2014, 78, 510–543. [Google Scholar] [CrossRef] [PubMed]
- JB, K. Antibiotic-induced biofilm formation. Int. J. Artif. Organs 2011, 34, 737–751. [Google Scholar] [CrossRef]
- Penesyan, A.; Paulsen, I.T.; Gillings, M.R.; Kjelleberg, S.; Manefield, M.J. Secondary Effects of Antibiotics on Microbial Biofilms. Front. Microbiol. 2020, 11, 2109. [Google Scholar] [CrossRef] [PubMed]
- Pei, R.; Lamas-Samanamud, G.R. Inhibition of biofilm formation by T7 bacteriophages producing quorum-quenching enzymes. Appl. Envion. Microbiol. 2014, 80, 5340–5348. [Google Scholar] [CrossRef] [PubMed]
- Eskenazi, A.; Lood, C.; Wubbolts, J.; Hites, M.; Balarjishvili, N.; Leshkasheli, L.; Askilashvili, L.; Kvachadze, L.; van Noort, V.; Wagemans, J.; et al. Combination of pre-adapted bacteriophage therapy and antibiotics for treatment of fracture-related infection due to pandrug-resistant Klebsiella pneumoniae. Nat. Commun. 2022, 13, 302. [Google Scholar] [CrossRef] [PubMed]
- Liu, S.; Lu, H.; Zhang, S.; Shi, Y.; Chen, Q. Phages against Pathogenic Bacterial Biofilms and Biofilm-Based Infections: A Review. Pharmaceutics 2022, 14, 427. [Google Scholar] [CrossRef]
- Laanto, E.; Mäkelä, K.; Hoikkala, V.; Ravantti, J.J.; Sundberg, L.R. Adapting a Phage to Combat Phage Resistance. Antibiotics 2020, 9, 291. [Google Scholar] [CrossRef]
- Sharma, G.; Sharma, S.; Sharma, P.; Chandola, D.; Dang, S.; Gupta, S.; Gabrani, R. Escherichia coli biofilm: Development and therapeutic strategies. J. Appl. Microbiol. 2016, 121, 309–319. [Google Scholar] [CrossRef]
- Surgers, L.; Boyd, A.; Girard, P.-M.; Arlet, G.; Decré, D. Biofilm formation by ESBL-producing strains of Escherichia coli and Klebsiella pneumoniae. Int. J. Med. Microbiol. IJMM 2019, 309, 13–18. [Google Scholar] [CrossRef]
- Whelan, S.; O’Grady, M.C.; Corcoran, D.; Finn, K.; Lucey, B. Uropathogenic Escherichia coli Biofilm-Forming Capabilities are not Predictable from Clinical Details or from Colonial Morphology. Diseases 2020, 8, 11. [Google Scholar] [CrossRef] [PubMed]
- Zhou, F.; Wang, D.; Hu, J.; Zhang, Y.; Tan, B.K.; Lin, S. Control Measurements of Escherichia coli Biofilm: A Review. Foods 2022, 11, 2469. [Google Scholar] [CrossRef] [PubMed]
- Folliero, V.; Franci, G.; Dell’Annunziata, F.; Giugliano, R.; Foglia, F.; Sperlongano, R.; De Filippis, A.; Finamore, E.; Galdiero, M. Evaluation of Antibiotic Resistance and Biofilm Production among Clinical Strain Isolated from Medical Devices. Int. J. Microbiol. 2021, 2021, 9033278. [Google Scholar] [CrossRef] [PubMed]
- Donadu, M.G.; Ferrari, M.; Mazzarello, V.; Zanetti, S.; Kushkevych, I.; Rittmann, S.K.-M.R.; Stájer, A.; Baráth, Z.; Szabó, D.; Urbán, E.; et al. No Correlation between Biofilm-Forming Capacity and Antibiotic Resistance in Environmental Staphylococcus spp.: In Vitro Results. Pathogens 2022, 11, 471. [Google Scholar] [CrossRef]
- Visnapuu, A.; Van der Gucht, M.; Wagemans, J.; Lavigne, R. Deconstructing the Phage-Bacterial Biofilm Interaction as a Basis to Establish New Antibiofilm Strategies. Viruses 2022, 14, 1057. [Google Scholar] [CrossRef]
- Ceri, H.; Olson, M.E.; Stremick, C.; Read, R.R.; Morck, D.; Buret, A. The Calgary Biofilm Device: New Technology for Rapid Determination of Antibiotic Susceptibilities of Bacterial Biofilms. J. Clin. Microbiol. 1999, 37, 1771–1776. [Google Scholar] [CrossRef]
- Stepanović, S.; Vuković, D.; Hola, V.; Di Bonaventura, G.; Djukić, S.; Cirković, I.; Ruzicka, F. Quantification of biofilm in microtiter plates: Overview of testing conditions and practical recommendations for assessment of biofilm production by staphylococci. APMIS 2007, 115, 891–899. [Google Scholar] [CrossRef] [PubMed]
- McCallin, S.; Sarker, S.A.; Sultana, S.; Oechslin, F.; Brüssow, H. Metagenome analysis of Russian and Georgian Pyophage cocktails and a placebo-controlled safety trial of single phage versus phage cocktail in healthy Staphylococcus aureus carriers. Env. Microbiol. 2018, 20, 3278–3293. [Google Scholar] [CrossRef]
- Kutateladze, M. Experience of the Eliava Institute in bacteriophage therapy. Virol. Sin. 2015, 30, 80–81. [Google Scholar] [CrossRef] [PubMed]
- Merabishvili, M.; Pirnay, J.P.; De Vos, D. Guidelines to Compose an Ideal Bacteriophage Cocktail. Methods Mol. Biol. 2018, 1693, 99–110. [Google Scholar] [CrossRef]

| N | Strain Code | Age | Sex | Type of UTI | Comorbidities |
|---|---|---|---|---|---|
| 1 | 021UR | 21 | Female | Pyelonephritis | Non |
| 2 | 01032UR | 66 | Male | Pyelonephritis | Diabetes mellitus; CKD IIIB; Nephrolithiasis; Essential arterial hypertension; Coronary artery disease; Congestive heart failure |
| 3 | 0108UR | 30 | Female | Asymptomatic bacteriuria | Renal transplantation 2013; CKD V; FSGS; Haemodialysis; Renal anaemia; Secondary hypertension |
| 4 | 01108UR | 74 | Female | Cystitis | Coronary artery disease; Essential arterial hypertension; Osteoarthritis; Hypothyroidism; Congestive heart failure |
| 5 | 01168UR | 49 | Female | Cystitis | Renal transplantation 2016; Acute CMV hepatitis; Secondary hypertension; Multiple sclerosis; |
| 6 | 01206UR | 57 | Female | Recurrent cystitis | Renal transplantation 2008; CKD IIIB; Recurrent UTI; Secondary hypertension; |
| 021UR | 01032UR | 01081UR | 01108UR | 01168UR | 01206UR | |
|---|---|---|---|---|---|---|
| AMP | R | R | S | S | R | R |
| AMC | R | R | S | S | S | S |
| TZP | S | I | S | S | S | S |
| CTX | S | R | S | S | S | S |
| CAZ | S | R | S | S | S | S |
| IMP | S | S | S | S | S | S |
| MEM | S | S | S | S | S | S |
| CIP | S | R | S | S | S | R |
| NOR | S | N/A | N/A | N/A | S | R |
| GEN | S | R | S | S | S | S |
| SXT | R | S | S | S | R | S |
| NIT | S | S | S | S | S | S |
| ESBL | Negative | Positive | Negative | Negative | Negative | Negative |
| Ses | ++ | + | ++ | + | ++ | - |
| Intesti | +++ | + | ++ | - | + | - |
| Pyobacteriophag | ++ | + | + | - | + | + |
| Pyobacteriophag * | N/A | N/A | N/A | N/A | N/A | +++ |
| Biofilm formation | Moderate | Weak | Weak | No biofilm | Weak | Strong |
| Bacterial Strain | Inoculum | Planktonic Cells (after 24 h) | Biofilm Formatting Cells (after 24 h) | Biofilm Formatting Cells (after 48 h) |
|---|---|---|---|---|
| 021UR | 107 CFU/mL | 109 CFU/mL | 106 CFU/mL | 107 CFU/mL |
| 01206UR | 107 CFU/mL | 109 CFU/mL | 106 CFU/mL | 107 CFU/mL |
Publisher’s Note: MDPI stays neutral with regard to jurisdictional claims in published maps and institutional affiliations. |
© 2022 by the authors. Licensee MDPI, Basel, Switzerland. This article is an open access article distributed under the terms and conditions of the Creative Commons Attribution (CC BY) license (https://creativecommons.org/licenses/by/4.0/).
Share and Cite
Mukane, L.; Racenis, K.; Rezevska, D.; Petersons, A.; Kroica, J. Anti-Biofilm Effect of Bacteriophages and Antibiotics against Uropathogenic Escherichia coli. Antibiotics 2022, 11, 1706. https://doi.org/10.3390/antibiotics11121706
Mukane L, Racenis K, Rezevska D, Petersons A, Kroica J. Anti-Biofilm Effect of Bacteriophages and Antibiotics against Uropathogenic Escherichia coli. Antibiotics. 2022; 11(12):1706. https://doi.org/10.3390/antibiotics11121706
Chicago/Turabian StyleMukane, Laima, Karlis Racenis, Dace Rezevska, Aivars Petersons, and Juta Kroica. 2022. "Anti-Biofilm Effect of Bacteriophages and Antibiotics against Uropathogenic Escherichia coli" Antibiotics 11, no. 12: 1706. https://doi.org/10.3390/antibiotics11121706
APA StyleMukane, L., Racenis, K., Rezevska, D., Petersons, A., & Kroica, J. (2022). Anti-Biofilm Effect of Bacteriophages and Antibiotics against Uropathogenic Escherichia coli. Antibiotics, 11(12), 1706. https://doi.org/10.3390/antibiotics11121706

